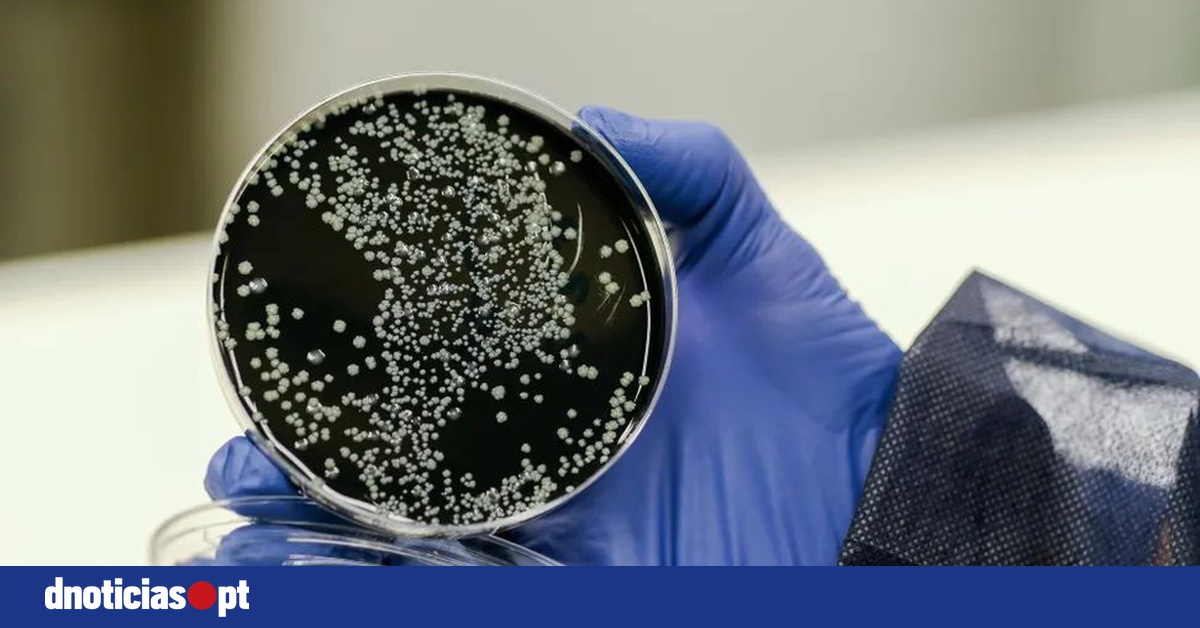
DNOTICIAS.PT

Detectada 'legionella' em lar de idosos de Lagos sem registo de infetados

A Santa Casa da Misericórdia de Lagos, no Algarve, revelou hoje que foi detetada a presença da bactéria 'legionella' no Lar São João Batista, em Barão de São João, sem que haja registo de pessoas infetadas.
Numa nota publicada na sua página de Internet, a instituição refere que até ao momento, "não foram registados" quaisquer sintomas associados à doença dos legionários entre utentes ou trabalhadores da instituição.
De acordo com a instituição de solidariedade social, a presença da bactéria 'Legionella spp.' foi detetada no âmbito do programa de vigilância sanitária da doença dos legionários pela Unidade Local de Saúde Pública.
A Misericórdia de Lagos garante que os serviços técnicos "adotaram medidas imediatas" para a eliminação e controlo do risco recomendadas pelas autoridades de saúde pública.
Ao mesmo tempo, adianta, estão a ser desenvolvidos todos os esforços para a rápida normalização do funcionamento do Lar de São João Batista, situado naquele concelho do distrito de Faro.
Segundo a Misericórdia de Lagos, o lar de idosos "reúne todas as condições de segurança e saúde" para os utentes, trabalhadores, familiares e visitantes da instituição.
A doença do legionário, provocada pela bactéria 'legionella pneumophila', contrai-se por inalação de gotículas de vapor de água contaminada (aerossóis) de dimensões tão pequenas que transportam a bactéria para os pulmões, depositando-a nos alvéolos pulmonares.